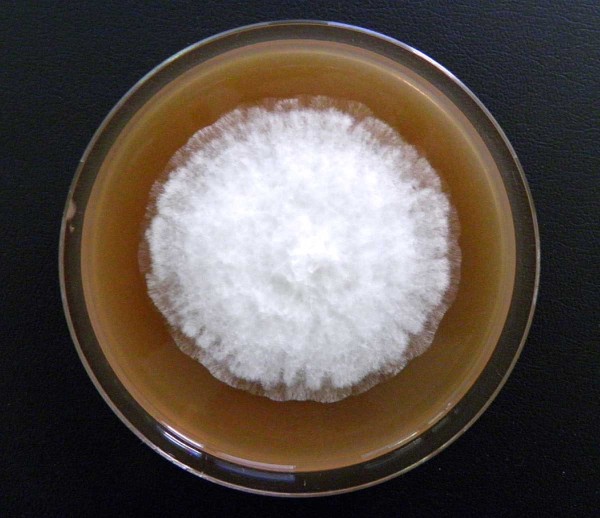
Obr. 3: Kolonie Phytophthora ramorum na&nbsp;V8-juice agaru
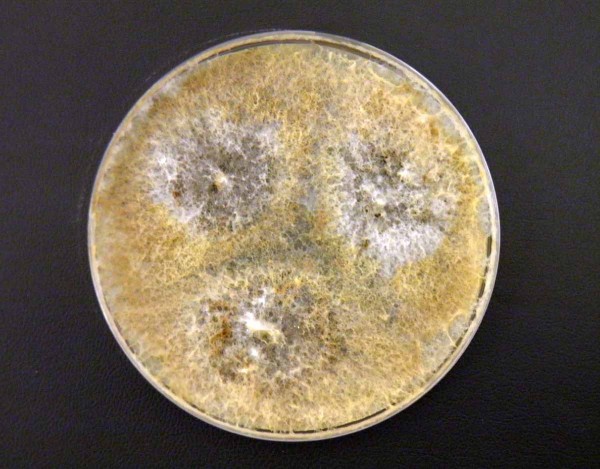
Obr. 4: Kolonie Cryptostroma corticale na&nbsp;MEA

Nové druhy houbových patogenů na dřevinách a okrasných rostlinách (I.)
23. 10. 2021 Choroby Zobrazeno 294x
Jednou z největších výzev v rostlinolékařství, pěstování zemědělských plodin, lesních dřevin, okrasných a dalších rostlin je nepochybně zavlékání nepůvodních druhů škůdců a patogenů. Fenomén zavlékání těchto organizmů je stejně starý jako zemědělství samo, nárůst jeho významu je však výrazněji spjat až s počátkem novověku a zejména nastupujícími hlubokými celospolečenskými změnami koncem 18. a počátku 19. století.
Zavádění a šíření nových plodin a intenzifikace zemědělské produkce vedly k nárůstu významu nechtěně zavlečených nepůvodních druhů patogenů, které dlouhou dobu měly (a místy stále mají) velmi závažné následky i pro lidskou populaci - vzpomeňme např. šíření Phytophthora infestans a následný hladomor i jeho další vlny zasahující v Evropě hluboko do 20. století nebo význam patogenů, jako jsou např. Magnaporthe oryzae, Puccinia graminis či Ustilago maydis, které mohou ohrožovat potravinovou bezpečnost některých společností či komunit.
Postupné rozšiřování zájmu o další rostlinné komodity (např. exotické okrasné rostliny a dřeviny), a intenzivní rozvoj obchodních vztahů v rámci koloniálních velmocí a později globalizace a postupné stírání významu geografických bariér bránících šíření těchto organizmů pak vedly ke stále se zvyšujícímu počtu nechtěných introdukcí. Tyto patogeny, snad i pro menší význam pro zemědělství a potravinovou produkci a mnohdy metodicky obtížnější uchopitelnost, ovšem někdy zůstávaly mimo dosah významnějšího zájmu odborníků a společnosti - dokud samozřejmě v kulturách nezpůsobily výraznější škody či dokonce v nových areálech nezdomácněly a neunikly do přírodního prostředí. Těmto někdy méně studovaným či známým invazním patogenům je věnována krátká série článků počínající tímto dílem.
Invaze patogenů rostlin v Evropě a na území ČR
První výskyty nepůvodních invazních patogenů rostlin na území Evropy a ČR byly dokladovány již od 18. století (např. Tilletia caries), mnohé však byly nepochybně zavlečeny podstatně dříve spolu se svými hostiteli. Intenzivní rozvoj fytopatologie a mykologie v průběhu 19. století vedl k rychlé identifikaci řady parazitů rostlin - ve valné většině se samozřejmě jednalo o významné patogeny zemědělských plodin a patogeny nadzemních částí rostlin vyvolávající choroby s nápadnými symptomy (např. rzi, sněti apod.).
První výskyty skrytě žijících (ale často velmi významných) patogenů kořenových systémů a krčků rostlin (Pythiales) byly v Evropě popisovány výjimečně již od počátku 19. stol. (P. cambivora způsobující inkoustovou nemoc kaštanovníku pravděpodobně díky nápadným projevům; obr. 1), četnější výskyty však byly zjištěny až v průběhu 19. a hlavně ve 20. století.
Mnohé z těchto druhů byly jako polyfágní zaznamenávány současně z nejrůznějších hostitelů a prostředí. Takovým příkladem je např. polyfágní oomycet P. cactorum, prvně identifikovaný jako významný patogen kaktusů (např. Carnegiea gigantea) ve skleníkových sbírkách významného botanika a propagátora pěstování sukulentů von Jacobiho ve Vratislavi (v prozaickém civilním životě pak generála pruského dělostřelectva), dnes extrémně významný patogen zemědělských plodin (ovoce), ale i okrasných rostlin a lesních dřevin. Tyto a mnohé další významné oomycety ovšem byly na území našeho státu dokladovány obvykle až mnohem později.
Důkladná práce mnoha výjimečných kryptogamologů působících v českých zemích počínaje Cordou a nikoliv snad konče Bubákem vedla ve druhé polovině 19. století k identifikaci řady patogenů - a to i nepůvodních (graf); ve valné většině se opět logicky jednalo o významné patogeny zemědělských plodin a patogeny nadzemních částí rostlin vyvolávající choroby s nápadnými symptomy. První výskyty nepůvodních invazních patogenů dřevin a okrasných rostlin jsou (prozatím) doloženy z roku 1818 (jak jinak, rzí: Gymnosporangium tremelloides, Puccinia gentianae, Uromyces rumicis; nepochybně však při důkladném hodnocení herbářových materiálů budou zjištěny i datace starší), poslední údaje pochází z roku 2020.
Do současné doby byl na území ČR ověřen výskyt více než 500 nepůvodních patogenů rostlin (včetně zemědělských plodin), z toho prozatím u téměř 400 druhů disponujeme relativně přesnými údaji o prvním záchytu (výsledky jsou ovšem průběžně zpřesňovány na základě dalších prací).
Kumulativní počet zaznamenaných nepůvodních patogenů rostlin po počátečním „zakladatelském boomu“ kolem poloviny 19. století narůstal víceméně lineárně (počty samozřejmě v jednotlivých dekádách kolísaly v závislosti na aktivitách výzkumníků) až do konce 30. let minulého století. Výrazná změna ovšem nastala v posledních šesti až sedmi dekádách, kdy nárůst počtu druhů nejprve v průběhu 40. let nápadně klesl, aby později získal exponenciální charakter, který dosud přetrvává (graf). Za tento poslední charakteristický nárůst, který je popisován prakticky všude ve světě, je zodpovědný zejména vzrůstající význam mezinárodního obchodu rostlinným materiálem a postupující globalizace.
Do jisté míry lze předpokládat i efekt zvýšené pozornosti vědecké komunity věnované této významné problematice. Vývoj kumulativního počtu nepůvodních patogenů rostlin může významně odrážet i jiné společenské události - např. pro ČR (a pravděpodobně celý bývalý východní blok) je charakteristický již zmíněný malý počet záchytů počínající válečnými lety a končící pádem železné opony. Za tato nízká čísla je jistě alespoň zčásti odpovědná hospodářská, resp. socioekonomická izolace bloku. Po propojení ekonomik v rámci EU i celosvětové obchodní sítě v posledních dvou dekádách ovšem množství záchytů nepůvodních patogenů vzrůstá dokonce rychleji než ve „starých“ unijních zemích.
Graf: Četnost datovaných záchytů nepůvodních patogenů rostlin na území ČR od roku 1800

Obr. 1: Pohlavní orgány Phytophthora cambivora

Obr. 2: Plodnice Hymenoscyphus fraxineus na opadu jasanu
Obr. 3: Kolonie Phytophthora ramorum na V8-juice agaru
Situace na území ČR
Podrobnější analýza výskytu nepůvodních patogenů na okrasných rostlinách a dřevinách za posledních 20 let potvrdila na území ČR výskyt cca 80 nových druhů, plus bylo určeno dalších cca 120 druhů vyskytujících se na území Evropy, které by mohly být s větší či menší mírou pravděpodobnosti zjištěny i u nás, či by mohly být v blízké budoucnosti k nám zavlečeny. Z těchto cca 200 aktuálně zaznamenaných a šířících se organizmů patří do Oomycetes 45 taxonů, dále jsou zastoupeny Dothideomycetes (38 taxonů), Sordariomycetes (36), Erysiphales (32), Helotiales (21) a Uredinales (21).
Lze kvalifikovaně odhadnout, že z identifikovaných cca 200 taxonů zhruba až 1/5 představuje či může představovat poměrně závažné riziko pro pěstování kulturních rostlin (dřevin a okrasných rostlin, případně i některých zemědělských plodin), největší rizika lze spatřovat u zástupců Oomycetes a Sordariomycetes.
Nejméně prozkoumanou a zároveň nejvíce rizikovou skupinou (mj. i z hlediska hybridizace) jsou oomycety. Vzhledem k postupující globalizaci a dalším problémům (mj. nedostatečná efektivita fytosanitárních bariér) lze však předpokládat, že se mohou u nás (resp. v Evropě) objevit i druhy naprosto nové a neočekávané a se značným škodlivým potenciálem podobně náhle jako např. Hymenoscyphus fraxineus (obr. 2) nebo některé druhy rodu Phytophthora (např. P. ramorum - obr. 3).
Diverzita a původ invazních druhů a cesty zavlékání
Počet zaznamenaných nepůvodních druhů patogenů na konkrétním území závisí na mnoha faktorech - jedním z nejvýznamnějších je jeho rozloha. V rámci Evropy jsou invazemi nejvíce postiženy geograficky rozsáhlé země Francie, Anglie, Španělsko, Německo a Itálie s vhodným klimatem a exponovanou polohou - významný vliv má totiž např. i četnost letišť a přístavů a samozřejmě historický vývoj konkrétního státu.
Není jistě náhodou, že jedněmi z nejvíce invazemi zatížených evropských zemí jsou bývalé koloniální velmoci - na prvním místě samozřejmě Anglie. Evropa se tak kvůli právě tomuto historickému aspektu stala prvním, invazemi patogenů významně zatíženým regionem; ostatní intenzivně se rozvíjející části světa s postupující globalizací Evropu rychle dohnaly či dohánějí.
Počet zaznamenaných patogenů také závisí na šíři environmentálních podmínek a úrovni antropogenní zátěže krajiny. Významným faktorem je rovněž množství srážek - alespoň u některých skupin patogenů, jako jsou padlí či oomycety a dále např. hustota dopravní sítě apod. Velký vliv má obecně objem zahraničního obchodu, zejména pak s rostlinným materiálem a aktivita a otevřenost ekonomiky. Pokud budeme konkrétní a aktuální, značný význam má i objem zahradnické (školkařské) produkce a tradice v oboru - některé firmy sídlící v západoevropských „zahradnických velmocích“ jsou již notoricky známým zdrojem asymptomatického kontaminovaného rostlinného materiálu distribuovaného v tuzemské obchodní síti.
Největší část nepůvodních invazních houbových patogenů v Evropě pochází ze Severní Ameriky (51 %), následované Asií (28 %) a dalšími světadíly, přičemž v poslední době významně narůstá podíl invazí z východní Asie, čemuž se samozřejmě nelze divit. Přes všechnu snahu a pro náročnost výzkumů se původní areály mnoha invazních druhů daří identifikovat jen velmi pomalu a u mnoha druhů zůstáváme stále jen u více či méně pravděpodobných předpokladů (např. Ophiostoma novo-ulmi) nebo areály neznáme vůbec - takové organizmy jsou pak označovány jako kryptogenní (např. donedávna Phytophthora ramorum).
Většina patogenů byla do Evropy a nepochybně i na území ČR zavlečena jako nechtěná kontaminace rostlinného materiálu - nejčastěji přímo živých rostlin (platí zejména pro biotrofní patogeny), jiné byly zavlečeny spolu s dřevní hmotou - např. Ophiostoma novo-ulmi nebo pravděpodobně i Cryptostroma corticale (obr. 4) a Eutypella parasitica. Zavlékání spolu se semeny je relativně méně běžné, lze jej například předpokládat u Sphaeropsis sapinea, významného patogenu borovic, jehož acervuly se mj. běžně vytvářejí i na šiškách nebo u některých sypavek. U některých významných patogenů produkujících velké množství infekčních partikulí na nadzemních částech rostlin pak nelze vyloučit i dálkový přenos (např. Melampsoridium hiratsukanum).
Obr. 4: Kolonie Cryptostroma corticale na MEA

Obr. 5: Břehový porost olše lepkavé poškozený druhem Phytophthora alni
Význam invazních patogenů dřevin a okrasných rostlin
Význam nepůvodních invazních patogenů a možné dopady chorob, které způsobují (tzv. emerging infectious diseases, zkráceně EIDs), jsou dosud obvykle podceňovány. Riziko samozřejmě představují primárně pro nové hostitele, kteří vzhledem k chybějící koevoluci nemusí mít vyvinuty dostatečně efektivní rozpoznávací a obranné mechanizmy. V důsledku rozvoje EIDs pak dochází obvykle k větší či menší redukci početnosti populace hostitelů s následným rizikem eroze genofondu nebo dokonce kolapsu zbytkové populace v důsledku náhodné události nebo Alleeho efektu. Významný úbytek populace invadovaného druhu ovšem může mít často i různý kaskádový efekt v celé řadě dalších oblastí.
Škody způsobené invazními nepůvodními patogeny můžeme identifikovat ve všech oblastech pěstování citlivých hostitelů - od školkařství a okrasného zahradnictví, přes městskou zeleň, ovocnářství, až po vodohospodářství, lesnictví a ochranu přírody a krajiny (jednotlivé případy budou představeny v dalších dílech). Zdomácnělé šířící se patogeny pak způsobují značné ekonomické škody, ale mnohdy i mnohem významnější a hůře napravitelné škody environmentální.
Vyjádření ekonomických škod způsobených nepůvodními zdomácnělými patogeny dřevin, jakkoli je velmi potřebné, je samozřejmě obtížné z řady důvodů - mj. i proto, že je obtížné postihnout veškeré škody včetně ekosystémových služeb, které nelze opomíjet.
Snadno lze vyjádřit škody např. ve školkařských a zahradnických podnicích, které v jednotlivých provozech mohou dosahovat deseti- a statisícových (v případě drobnějších provozů) až miliónových částek; např. škody na produkci jasanů v důsledku šíření H. fraxineus byly v ČR vyčísleny v roce 2012 na cca 1,33 mil. Kč.
Druhým extrémem jsou pak např. škody způsobené Phytophthora alni v břehových porostech (obr. 5) - v rámci studie v oblasti povodí Vltavy bylo zjištěno, že průměrná výše škod v břehových porostech olší dosahuje cca 35 tis. Kč na 100 m porostu (podle vyhlášky č. 441/2013 Sb. Ministerstva financí) a 56,5 tis. Kč podle metody nákladové. Celkové škody v povodí Vltavy se v současné době s největší pravděpodobností pohybují v řádu mld. Kč.
Jiným obdobným případem je zhodnocení potenciálních škod invaze Phytophthora ramorum na dubech v Kalifornii, kdy se ukázalo, že během let 2010–2020 mohly náklady na ošetření, odstranění a náhradu napadených dubů dosáhnout 7,5 mil. dolarů, přičemž pokles ceny majetku (nemovitostí s výskytem poškozených dřevin) může dosáhnout 135 miliónů dolarů. Podobné náklady (v našich reáliích samozřejmě) pak jsou vynakládány na odstraňování či ošetřování dřevin rostoucích mimo les poškozených u nás zdomácnělými nepůvodními patogeny - v dnešní době zejména Hymenoscyphus fraxineus.
Nejzávažnější rizika vyplývající ze zdomácnění nepůvodních patogenů dřevin spočívají v narušení a poškození celého biotopu či ekosystému, což přichází v úvahu tehdy, pokud je napaden jeden či dokonce více klíčových druhů dřevin společenstva a dojde k jeho plošnému odumírání. Nejznámější příklad této situace je invaze extrémně polyfágního druhu Phytophthora cinnamomi (doloženo je více než 5 000 hostitelských druhů) v Austrálii a hromadného odumírání hostitelských dřevin - klíčových druhů společenstev (zejména eukalyptů rodu Monocalyptus), v jehož důsledku dochází k poklesu zápoje stromového patra, poklesu primární produkce společenstva, ke změnám mikroklimatických poměrů a ke zvýšení eroze. Poškozeny jsou ovšem celé populace dvouděložných i jednoděložných rostlin (např. žlutokap Xanthorrhoea spp.) poskytující úkryt a potravu mnoha druhům drobných živočichů, jejichž populace jsou tak rovněž postiženy. V invadovaných společenstvech mizí citlivé druhy bylin (některé se podařilo zachránit před vyhynutím převedením do kultury) a šíří se druhy trav, které jsou schopny rychlé regenerace.
Zvýšení půdní eroze a poškození ekosystémových služeb (např. snížení fixace CO2, redukce klimatizační funkce aj.) byly prokázány či jsou předpokládány u celé řady patogenů, např. invaze Phytophthora lateralis v porostech cypřišku nutkajského v Severní Americe, Seiridium cardinale v porostech cypřiše stálezeleného ve Středomoří, invaze Hymenoscyphus fraxineus v porostech na svazích Alp, Phytophthora austrocedri poškozuje společenstva s dominantním cedrem chilským v Andách v Jižní Americe, Phytophthora ramorum představuje zásadní problém pro společenstva doubrav s dominantním Lithocarpus densiflorus a dalšími duby zase na západním pobřeží Severní Ameriky a mnohé další.
Z ČR lze např. připomenout nejznámější případ Phytophthora alni nevratně poškozující břehové porosty (obr. 5), mokřadní olšiny a spolu s Hymenoscyphus fraxineus potočiny. Význam P. alni ovšem opět nelze shledávat jen v přímém poškození napadených jedinců, jeho vliv je systémový a lze jej identifikovat či očekávat v dalších oblastech. Redukce olistění a zástinu vede ke změnám toku energie a živin (např. dusíku), snížení zástinu vede ke zvýšení teploty vody a významným změnám v biotě toků (nárůst biomasy řas), redukce kořenových systémů je příčinou zvýšené eroze břehu a změn v sedimentačních poměrech toků, zvýšení přísunu živin a polutantů splachy z okolí, redukce stanovišť řady bezobratlých závislých na členitých kořenových systémech v březích, které se zase mohou promítnout v potravní nabídce ryb a podobně.
Naše lužní lesy jsou pak postiženy např. invazemi Ophiostoma novo-ulmi, Hymenoscyphus fraxineus a Phytophthora plurivora.
Závěr
Druhá polovina 20. století a počátek století nynějšího jsou charakteristické exponenciálním nárůstem počtu zaznamenaných nepůvodních patogenů rostlin. Dnes tak čelíme, či spíše jsme svědky, bezprecedentní naturalizace a šíření mnoha druhů patogenů, jež mají za následek řadu závažných škod a trvalých změn v invadovaných systémech. Zabránění šíření a omezení vlivu invazních patogenů rostlin je extrémně náročné a pro dosažení efektivního výsledku musí dojít ke zlepšení v desítkách aspektů a aktivit v rámci výzkumu, výuky, státní správy i aplikační sféry; jejich rozbor je však nad rámec tohoto příspěvku.
Bohužel vytváření a zavádění včasných, efektivních a zároveň celospolečensky přijatelných opatření je v současné době spíše jen zbožným přáním, naopak můžeme spíše předpokládat další postupný nárůst aktivit nepůvodních invazních organizmů. Zdá se tak být nepochybné, že mnoha škodám dnes vznikajícím či budoucím nebude možné zabránit - spíše bude možné je jen do větší či menší míry omezit.
Hlavními používanými opatřeními v budoucnu, zejména v případě systémů více přírodních, budou tak pravděpodobně opatření adaptační založená na expertních a statistických modelech a predikcích, evaluacích citlivosti invazibilních kultur, lesních typů, společenstev a biotopů a tvorbě více či méně jednoduchých praktických opatření, které povedou alespoň k dílčímu omezení impaktu patogenů.
Článek vznikl za podpory výzkumného projektu TA ČR SS02030018 Centrum pro krajinu a biodiverzitu (DivLand).
Další články v kategorii Choroby











RSS
RSS